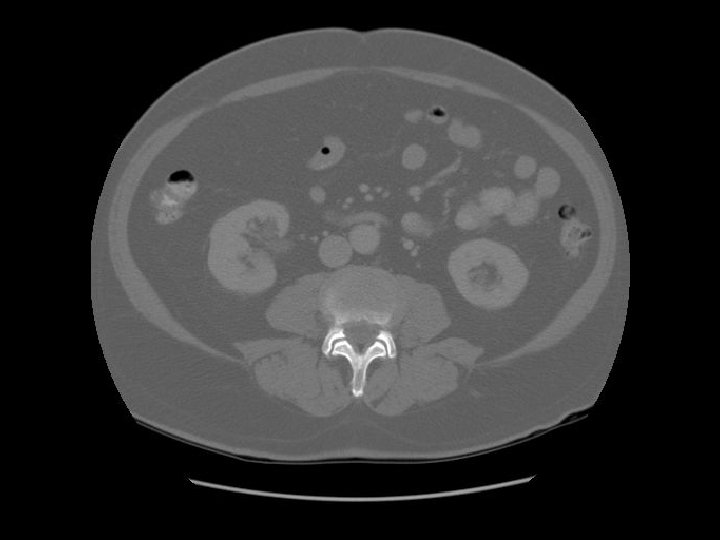

CT Chest and Abdomen for Beginners Arcot Chandrasekhar

CT Chest and Abdomen for Beginners Arcot Chandrasekhar, M. D. Hema Chandrasekhar, M. D.

Recommended way to use presentation: • Use it as a slide show. • Decide on one structure and follow the sequence, example aorta. • Next attempt to see its relationship to other structures. • Study it multiple times until you are comfortable in identifying each structure. • When in doubt, follow the structure above and below and it will become evident.

Exercises: First go through the entire sequence. 1. Follow axillary vein to superior vena cava entering right atrium. 2. Follow iliac veins to inferior vena cava entering right atrium. 3. Follow splenic vein to portal vein. 4. Follow aorta originating from LV to bifurcation to common iliac arteries. 5. Follow esophagus to rectum. 6. Follow trachea to RUL bronchus. 7. Follow SVC to RA to RV to main pulmonary artery and branches. 8. Focus on one structure and use the pg up/pg down option to follow it.

At the level of Contrast is injected in the right antecubital vein. Follow the contrast in the next few slides. Trachea Contrast in axillary vein Thyroid cartilage

Humerus Cervical spine Clavicle Scapula

Pectoralis major AC joint Supraspinatus

Thyroid Gland Thyroid gland First rib

First rib

Apex of lung

Rt common carotid artery Medial end of clavicle Rt subclavian artery Left

The subclavian vein joins the internal jugular vein to form the brachiocephalic vein behind the medial end of clavicle. Subclavian vein Right


Left common carotid artery Left subclavian artery

The brachiocephalic vein is also called the innominate vein.

Sternum

Because contrast was injected on the right side there is no visible contrast in left brachiocephalic vein. Left brachiocephalic vein Innominate vein

Brachiocephalic artery Left

A: Brachiocephalic artery B: Left common carotid artery C: Left subclavian artery A B C

See how the left brachiocephalic vein is joining the right brachiocephalic vein to become the superior vena cava.

Contrast in the right brachiocephalic vein has been diluted by blood from the left brachiocephalic vein as they combine to form the SVC.

Arch Aortic ofarch aorta SVC


Mediastinal fat

Scapula

Ascending aorta Main pulmonary artery Descending aorta

Contrast in SVC is diluted by blood from the azygous vein. Esophagus Azygous vein

Left pulmonary artery Carina

Right pulmonary artery Main pulmonary artery RUL bronchus Left pulmonary artery

Left main bronchus

SVC Intermediate bronchus LUL division

Ascending aorta

Rt atrium

Rt ventricle

Pulmonary vein Lt atrium



A: Aortic root RV RA A LV LA

Aortic valve


Rt ventricle Lt ventricle


Interventricular septum


Osteophyte

IVC

Liver Heart




Stomach GE junction Esophagus


Stomach Liver Spleen

Lt lobe Rt lobe

Fissure for ligamentum teres Fissure for ligamentum venosum

Caudate lobe Diaphragm


Caudate lobe Diaphragm

Portal vein

Lt adrenal

Portal vein Rt adrenal

Surgical clips in gallbladder fossa.

Coeliac trunk

Pancreas Splenic vein The splenic vein lies in the posterior pancreatic grove and joins the superior mesenteric vein to form the portal vein.

Pancreas Duodenal bulb IVC Rt renal artery The right renal artery is retrocaval.

Small cyst in the left kidney.

Lt renal vein IVC Left renal vein emptying into the IVC.


Transverse colon Ileum



Kidney Right Kidney

Descending colon Right



Renal pelvis



Ascending colon Right colon with fecal material.

Abdominal aorta about to bifurcate.

Psoas

Rt common iliac artery IVC Lt common iliac artery

L 5


Arrows are pointing to the common iliac veins joining to form the IVC. Left






Ilium Sacrum


Arrows are pointing to the internal and external iliac veins joining to form the common iliac vein.


Ilium Sacrum

Rectosigmoid Sacroiliac joint


Diverticula in recto sigmoid Rectosigmoid

Arrows are pointing to air filled diverticulum and the second one is filled with residual barium from an old GI study.




Gluteus

Bladder Seminal vesicle Rectum


Femoral artery Femoral vein

Bladder Prostate Rectum

Femoral head Acetabulum

Feces in the rectum

Pubic symphysis






Ischiorectal fossa


Shaft of penis




Femur
- Slides: 126